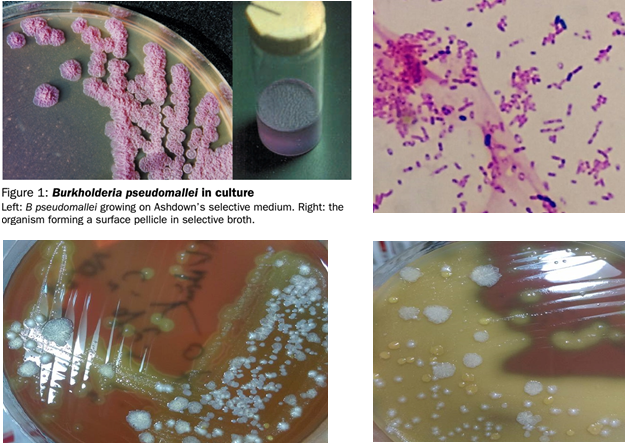

I. TỔNG QUAN
Bệnh Melioidosis là các bệnh lý nhiễm trùng do trực khuẩn Burkholderia pseudomallei gây ra, một vi khuẩn Gram âm sống trong môi trường đất mùn ẩm thường gặp ở vùng ĐNA và Bắc Australia, với bệnh cảnh đa dạng trên nhiều hệ cơ quan, thường liên quan đến những cơ địa bệnh mãn tính như ĐTĐ và phải sử dụng liệu pháp kháng sinh kéo dài để điều trị và phòng tái phát.
1. Lịch sử phát hiện
- Những báo cáo đầu tiên ở Rangoon (1911), Kuala Lumpur (1913): bệnh cảnh abscess đa cơ quan ở gan, phổi, lách, thận… giống với bệnh do Bacillus maleii ở ngựa à Melioidosis (Hy Lạp, melio là bệnh của ngựa, eidos là sự tương đồng).
- Những ca bệnh khác được phát hiện ở binh lính Pháp, Mỹ sau tham chiến ở Việt Nam, ở phía Bắc Australia, đặc biệt là serial case 800 ca bênh ở Thái Lan trong giai đoạn 1970-80, bức trang lâm sàng của bệnh Melioidosis mới sáng tỏ hơn.
- Vi khuẩn gây bệnh đã được phát hiện từ sớm nhưng đến 1992 mới có tên B.pseudomallei và đã được giải mã bộ gene.
- Ca bệnh đầu tiên báo cáo ở VN năm 1925, nhưng phải đến 1995 mới nuôi cấy phân lập được vi khuẩn.
2. Vi khuẩn Burkholderia pseudomallei
a. Đặc điểm vi sinh vật học
- Thuộc chi Burkholderia, gồm hơn 40 loài, gồm 1 số loài gây bệnh sưng hạch ở ngựa, gia súc nhưng rất hiếm gây bệnh ở người và độc lực thấp hơn B.peudomallei.
- Là trực khuẩn Gram âm ngắn, bắt màu mạnh ở 2 đầu, đứng riêng lẻ hoặc chuỗi ngắn,
- Vi khuẩn hiếu khí, không có vỏ, di động được bằng roi (flagella) và không tạo nha bào.
- Tồn tại nhiều năm trong tự nhiên như ở đất bùn, nước đọng và thường ở các ruộng lúa. Đề kháng tốt với các tác nhân lý hoá.
b. Tính chất nuôi cấy
- Mọc được ở hầu hết các môi trường nuôi cấy thông thường ở 37 độ C, nhưng có thể phát triển được từ 5-42 độ C.
- Trên nhuộm Gram: trực khuẩn Gram (-) hình kim băng
- Trên thạch đặc: sau 24h mọc khuẩn lạc dạng S nhẵn, 1-2mm, bóng; sau 48h thành dạng R nhăn nheo, mùi thơm như mùi nho.
- Trên môi trường lỏng pepton: làm đục môi trường và tạo váng dày, khô, nhăn nheo ở bề̀ mặt.
- Trên thạch máu: tạo khuẩn lạc tan máu.
- Một số test, kỹ thuật chẩn đoán khác: test oxidase (+), ngưng kết latex, ELISA, que thử test nhanh, PCR.
c. Sinh bệnh học:
- Vi khuẩn kí sinh nội bào trong cả đại thực bào và các tế bào không thực bào.
Vi khuẩn vào tế bào trong các túi thực bào, chúng thoát được khỏi túi, sắp xếp lại các sợi actin trong tế bào và tạo ra các nhú trên màng giúp lan truyền vi khuẩn sang tế bào khác.
- Gây bệnh chủ yếu qua các nội độc tố có bản chất phức hợp LPS-protide, có tạo ngoại độc tố nhưng vai trò chưa rõ ràng. Thường cự trú trong tế bào rất lâu mà ít khi gây vỡ tế bào à chờ đợi cơ thể suy yếu để biểu hiện bệnh.
- Do kí sinh nội bào, chúng có cơ chế đề kháng tự nhiên với nhiều loại kháng sinh, ngoài ra còn cơ chế kháng nữa là các bơm thuốc ra ngoài tế bào
II. Bệnh Melioidosis
1. Dịch tễ:
Phân bố của bệnh:
+ vùng dịch tễ: miền Bắc nước Úc, Thái Lan, Malaysia, Singapore, Việt Nam
+ vùng cận dịch tễ: miền Nam Trung Quốc, Lào, Hồng Khôngng, Đài Loan
+ vùng có phát hiện ca bệnh: châu Á (Nhật, Indo, Phillippines), châu Mỹ (Brazil, USA, Mexico), châu Phi và vùng Trung Đông.
+ Tại Việt Nam: Đoàn Mai Phương (2008) cho thấy vùng phân bố các ca bênh ở VN chủ yếu ở vùng đồng bằng Bắc Bộ và ven biển miền trung.
Đường lây:
+ chủ yếu là tiếp xúc trực tiếp qua da với nguồn đất, nước chứa mầm bệnh trong thời gian lâu dài
+ đường hít, nuốt phải
+ 1 số đường lây như qua máu, qua nhau thai, qua quan hệ tình dục, từ động vật sang người tuy rất hiếm nhưng đã có một số báo cáo nghi ngờ
Yếu tố khí hậu: hơn 80% ca bệnh mắc vào mùa mưa, tỷ lệ mắc tăng gấp 3 lần.
Độ tuổi thường gặp: 40-60, có thể gặp ở trẻ em.
Nghề nghiệp: nông dân, người lao động tiếp xúc trực tiếp với đất, nước, đặc biệt tại các vùng trồng lúa nước.
Yếu tố nguy cơ:
+ Đái tháo đường
+ Nghiện rượu
+ Bệnh phổi mạn tính
+ Thalassemia
+ Bệnh thận mạn
+ Các tình trạng suy giảm hệ miễn dịch: cắt lách, dùng corticoid hay thuốc ức chế miễn dịch khác, ung thư (Leukemia). Tuy nhiên HIV lại không phải yếu tố liên quan đến nguy cơ mắc bệnh.
2. Các thể lâm sàng:
| | Thể cấp tính (80-90%) | Thể mạn tính (10-20%) |
| Thời gian ủ bệnh | 1-21 ngày (9 ngày) | Có thể rất lâu, hàng năm sau khi tiếp xúc nguồn bệnh |
| Thời gian biểu hiện triệu chứng | < 2 tháng | > 2 tháng |
| Bệnh cảnh | NKH, abscess đa tạng | Tổn thương khu trú 1 cơ quan |
| Cơ quan | Phổi, gan, lách, tuyến tiền liệt, thận, cơ, màng não, tim | 2 bệnh cảnh chính là viêm phổi và loét da kéo dài |
| | | Cần phải phân biệt với những trường hợp tái phát hoặc tái nhiễm |
Viêm phổi: thường gặp nhất (50%)
+ vi khuẩn thâm nhập vào đường hô hấp theo đường máu đến là chủ yếu so với đường hít vào.
+ khởi phát là tình trạng ho khan hoặc kèm máu, sốt, khó thở, đau ngực kiểu màng phổi, có thể kèm các biểu hiện của tình trạng nhiễm khuẩn mạn tính như sụt cân, ra mồ hôi trộm.
+ viêm phổi thường không điển hình, ít khi có đau ngực hay có HC đông đặc như viêm phổi thuỳ
+ Xquang: thâm nhiễm lan toả hoặc tổn thương đông đặc rải rác 1 hay vài thuỳ phổi, thường gặp ở thuỳ trên, có thể kèm tràn dịch, tràn mủ màng phổi; hoặc tổn thương dạng hang áp xe
Nhiễm khuẩn huyết: thường gặp trong thể cấp tính
+ Mang các tính chất điển hình của bệnh cảnh nhiễm khuẩn huyết do vi khuẩn Gram âm.
+ khởi phát từ 1-21 ngày (7-10 ngày) với các triệu chứng không đặc hiệu như sốt cao, đau nhức cơ toàn thân, sưng hạch lympho, tiêu chảy.
+ Tỷ lệ tiến triển thành shock nhiễm khuẩn cao (50%), suy đa tạng sau 24-48h toàn phát, dẫn tới tỷ lệ tử vong cao (50-90%).
+ Từ ổ nhiễm trùng ban đầu (thường từ da) vi khuẩn sẽ nhanh chóng xâm nhập và gây bệnh cảnh đến nhiều cơ quan trong giai đoạn toàn phát: triệu chứng của các ổ abscess di bệnh khắp cơ thể (phổi, da, gan, lách, thận, tuyến tiền liệt…).
- Tổn thương trên da cơ xương, phần mềm: thường không phải triệu chứng đầu tiên
+ Vết loét hoặc mụn mủ đơn độc hoặc nốt, lâu liền: thể mạn tính, có thể là nguyên phát.
+ Mụn mủ có viền ban đỏ toàn thân: thể cấp tính, xuất hiện thứ phát sau NKH.
+ Abscess phần mềm dưới da, viêm mô tế bào.
+ Viêm khớp nhiễm khuẩn và viêm tuỷ xương: có tính chất mạn tính.

3. Chẩn đoán:
- Do đặc điểm lâm sàng rất giống nhiều bệnh lý khác như lao, tụ cầu, nên hầu hết các trường hợp chẩn đoán được là sau khi có kết quả nuôi cấy vi sinh.
- Do đó, hãy nghĩ đến bệnh Whitmore khi có gợi ý về vùng dịch tễ địa phương, mùa mưa, nghề nghiệp và có yếu tố nguy cơ.
- Các mẫu bệnh phẩm cần được nuôi cấy ngay nếu nghi ngờ: máu, đờm, nước tiểu, dịch mủ hoặc dịch phết vết loét của ổn thương da, mủ abscess, dịch phết trực tràng.
- Nuôi cấy trên môi trường thạch Ashdown chứa gentamycin, test ngưng kết HC, ELISA, PCR.
4. Điều trị: Kháng sinh
Chia làm 2 giai đoạn: tấn công và dự phòng tái phát.
+ Điều trị tấn công:
Ceftazidime IV là lựa chọn đầu tay: VP, NKH, tổn thương đơn thuần
Meropenem, Imipenem được dùng cho trường hợp NKH có shock, BN vào ICU, có tổn thương hệ TKTW, hoặc có xuất hiện ổ nhiễm khuẩn mới hay cấy máu vẫn (+) sau 7 ngày điều trị
Cotrimoxazole được khuyến cáo nên phối hợp trong trường hợp tổn thương nhiều cơ quan, như: da, xương khớp, tuyến tiền liệt, hệ thần kinh. Không khuyến cáo nếu chỉ viêm phổi hoặc NKH không tổn thương cơ quan.
Thời gian giai đoạn tấn công:
NKH, VP đơn thuần, abscess da: 10-14 ngày
Viêm phổi nặng ICU, abscess tạng, NKH có di bệnh: 4 tuần
Viêm tuỷ xương, NK hệ TKTW: > 4 tuần
+ Giai đoạn dự phòng tái phát bằng đường uống: Cotrimoxazole trong 3-6 tháng, dị ứng thì thay bằng Doxycycline hoặc Amox-clavulanat.
| Giai đoạn tấn công | Ceftazidime | 50mg/kg, tối đa 2g, q6h |
| Meropenem | 25mg/kg, tối đa 1g, q8h |
| Imipenem | 25mg/kg, tối đa 1g, q6h |
| Giai đoạn duy trì | Cotrimoxazole | TE: 6/30 à 320/1200mg, q12h NL 40-60kg: 240/1200mg, q12h NL >60kg: 320/1600mg, q12h |
| Doxycycline | 2mg/kg, tối đa 100mg, q12h |
| Amox-Clavul | 20mg/kg theo Amox, q8h |
+ Điều trị bổ sung và dự phòng
Trích rạch, dẫn lưu ổ abscess nếu ổ đơn độc kích thước lớn, dưới da, nhưng không khuyến cáo nến là abscess đa ổ ở gan, lách.
Chọc hút dịch màng phổi, nội soi rửa ổ khớp nhiễm khuẩn
TE: acid folic 5mg mỗi ngày đường uống trong 3 tháng
Hiện chưa có vaccine dự phòng bệnh, dự phòng chủ yếu là tránh tiếp xúc trực tiếp với nguồn đất, nước tại vùng dich tễ trong mùa mưa, nhất là với đối tượng có yếu tố nguy cơ.
TỔNG KẾT
Melioidosis là bệnh nhiễm trùng do trực khuẩn Gram âm sống nội bào Burkholderia pseudomallei gây ra.
Bệnh biểu hiện lâm sàng đa dạng, từ không triệu chứng đến rất nặng như shock NK, dễ gây nhầm lẫn với nhiều căn nguyên khác. Tỷ lệ tử vong còn cao với thể bệnh cấp tính.
Yếu tố dịch tễ: vùng dịch tễ, mùa mưa, nông dân tiếp xúc trực tiếp với nguồn đất, nước có vi khuẩn, yếu tố nguy cơ (ĐTĐ, nghiện rượu, bệnh phổi, thận mạn tính…) à là những yếu tố gợi ý chẩn đoán.
Bệnh chưa được chú ý, hay chẩn đoán nhầm, phát hiện chủ yếu nhờ nuôi cấy ra căn nguyên.
Thời gian điều trị kéo dài, gồm 2 giai đoạn: tấn công và duy trì.
Chưa có vaccine phòng bệnh.